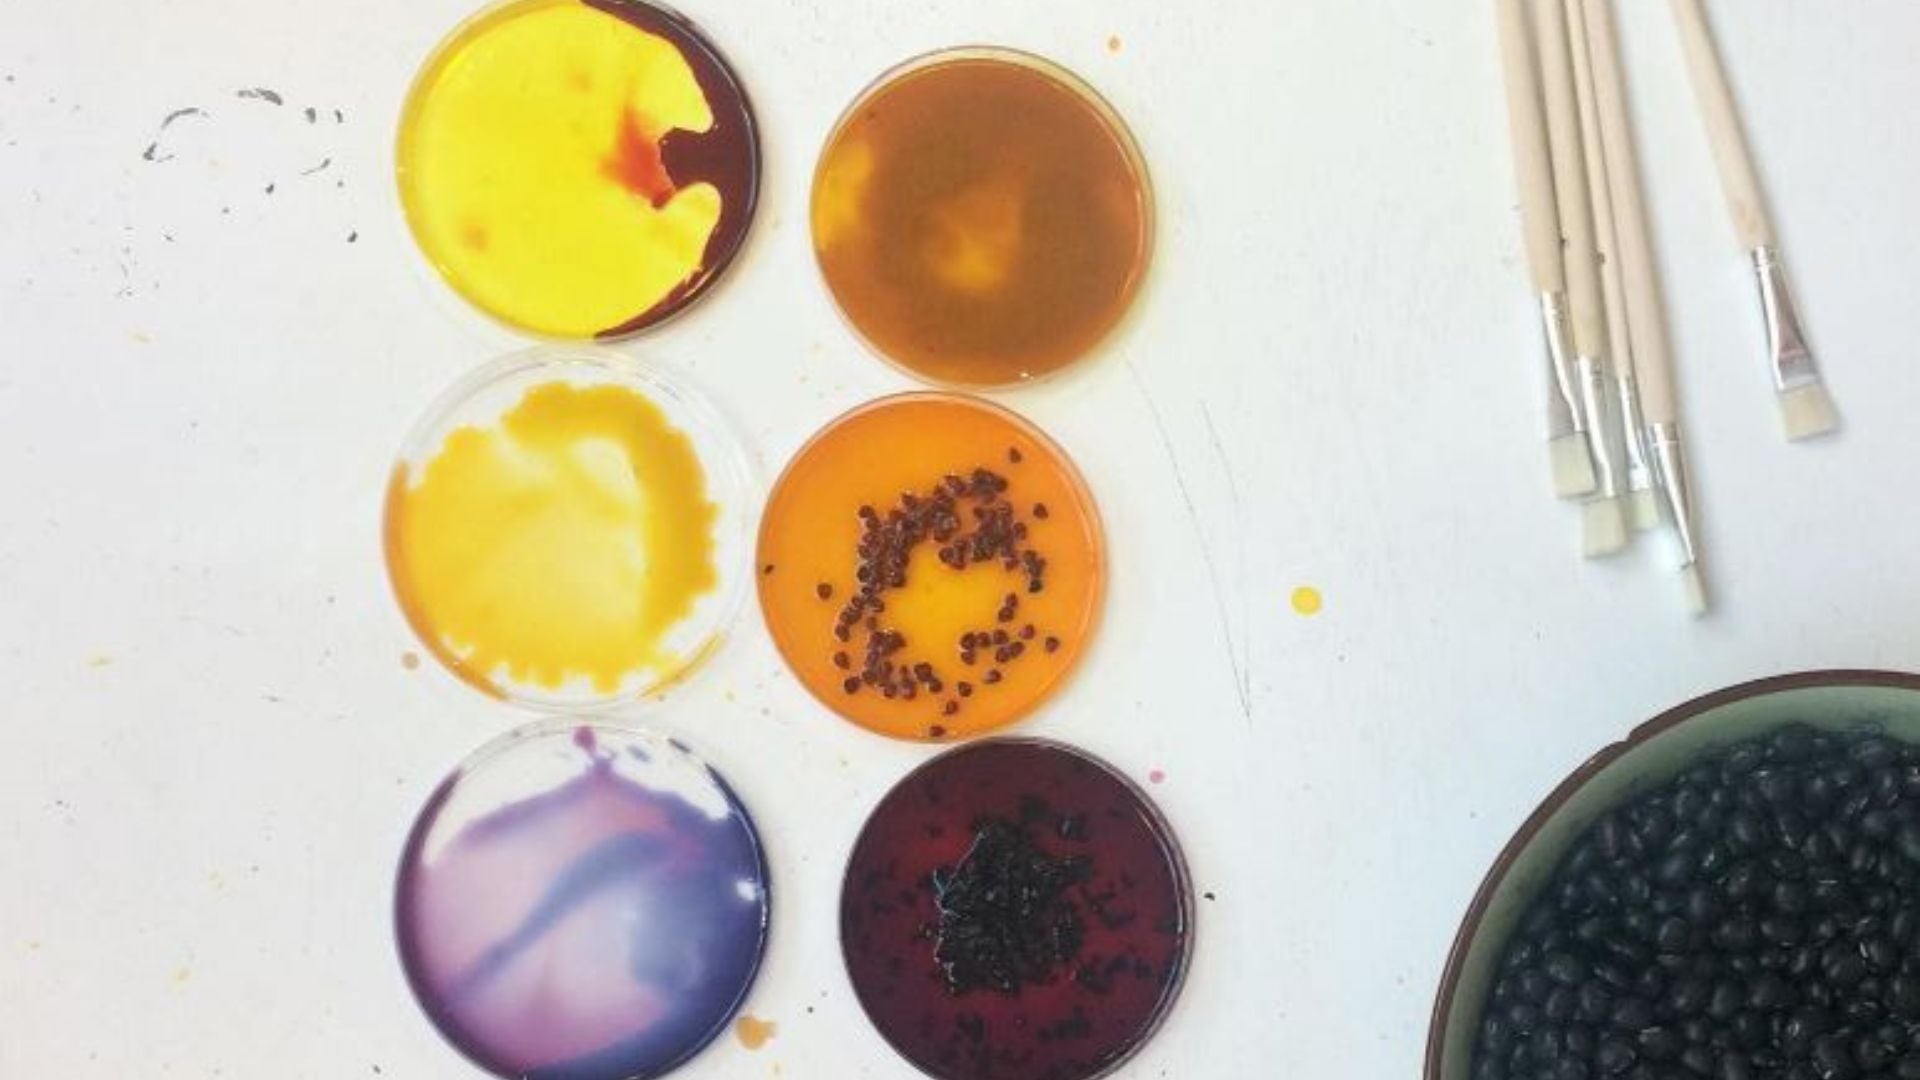
Atlas of Sustainable Colours

TIZZ & TONIC Blog & Articles

BIG CHANGES ARE COMING!
After 6 years of offering a wide range of intimates, it’s time to streamline. Smaller, more curated collections are coming your way & much more frequently. Pssst.. find us this month in Berlin, Paris & New...
BIG CHANGES ARE COMING!
After 6 years of offering a wide range of intimates, it’s time to streamline. Smaller, more curated collections are coming your way & much more frequently. Pssst.. find us this month in Berlin, Paris & New...

Leather out of grapes? Say what!? 🍇
Time to wine down with an interview with Samantha Mureau from Planet of the Grapes . Planet of the Grapes is a company founded by Samantha Mureau where she is...
Leather out of grapes? Say what!? 🍇
Time to wine down with an interview with Samantha Mureau from Planet of the Grapes . Planet of the Grapes is a company founded by Samantha Mureau where she is...
Atlas of Sustainable Colour(s)
Atlas of Sustainable Colour(s) - A home for all sustainable colour makers and users: dyers, designers, artists, startups and all people motivated by 'Colouriosity'. As you might know we are...
Atlas of Sustainable Colour(s)
Atlas of Sustainable Colour(s) - A home for all sustainable colour makers and users: dyers, designers, artists, startups and all people motivated by 'Colouriosity'. As you might know we are...

Fall '22 : Desert-Glam Vibes
Shooting our upcoming Fall looks was nothing short of magical. Although you may think at first glance we took a sneaky field trip to Marrakech, we actually shot all of...
Fall '22 : Desert-Glam Vibes
Shooting our upcoming Fall looks was nothing short of magical. Although you may think at first glance we took a sneaky field trip to Marrakech, we actually shot all of...

Our Packaging
Sustainability is a tricky business. Even with amazing eco-conscious products on the market, it's often the packaging that significantly contributes to the world’s biggest waste problems. Could there be a more...
Our Packaging
Sustainability is a tricky business. Even with amazing eco-conscious products on the market, it's often the packaging that significantly contributes to the world’s biggest waste problems. Could there be a more...

The Power of Colour
“From the moment I first started studying joy, it was clear that the liveliest places and objects all have one thing in common: bright, vivid color. Whether it’s a row...
The Power of Colour
“From the moment I first started studying joy, it was clear that the liveliest places and objects all have one thing in common: bright, vivid color. Whether it’s a row...